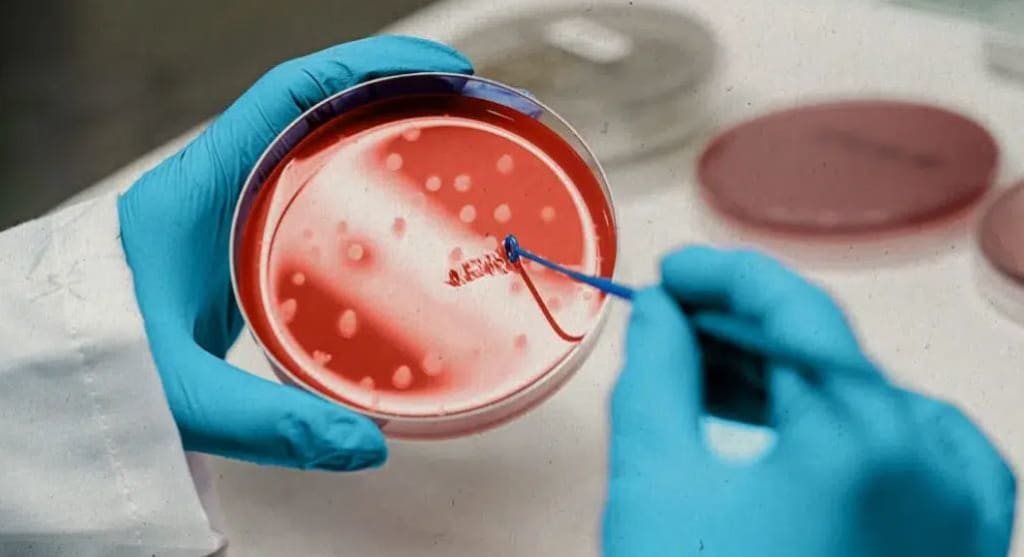

Buy Victoza Online at CanadianInsulin.com
Buy Victoza Online
Insulin products are gaining popularity because of their advantages, such as improving blood sugar control and decreasing the risk of type 2 diabetes. Finding the best deal on Victoza and comparing prices from different online retailers is essential. Let you get a reasonable price on the medicine while still getting it in Canada.
What is Victoza, and what are its benefits?
Victoza is a drug that is used to treat type 2 diabetes. It is a significant change in how diabetes is treated, as it uses a new way of targeting the pancreas. Victoza also has other benefits, such as helping to reduce weight and improve blood sugar control. Victoza (vitamins B6, B12, and Folate) is a prescription medication used to treat type 2 diabetes.
What is the cost of Victoza?
Victoza, a drug meant to lower blood sugar levels, can be expensive. The cost of the medication can depend on where you buy it and the dosage. The price of Victoza is high, but it may be a good choice for some people.
What is the best way to take Victoza?
There is no definitive answer to this question, as many factors can affect how effectively Victoza may be taken. However, some tips on how to take Victoza include:
1. Taking it regularly in divided doses;
2. Avoid drinking large amounts of water while taking Victoza;
3. Taking it with food or drink; and
4. Assuring dose accordingly.
What are the common side effects of the Victoza Pen?
A few side effects of Victoza can be frustrating for those who take the drug. One possible side effect is a decrease in blood sugar levels. Another potential side effect is an increased risk of developing pancreatitis, a type of pancreas inflammation. Finally, Victoza can also lead to hair loss and other problems with hair growth.
The side effects of Victoza are a range of possible side effects, which can vary from person to person. Some people may experience diarrhea, cramps, or even a headache after taking Victoza. Others may have trouble sleeping or having an empty stomach. Before taking Victoza, you must speak with your physician to have any initial questions addressed.
What are the possible interactions between Victoza and other medications?
There are many potential interactions between Victoza and other medications. These interactions can vary depending on the individual prescription and its interaction profile. If you are taking Victoza, be sure to speak with your doctor about potential possible interactions. Several medications interact with Victoza, including warfarin, prednisone, and azathioprine.
How do I take Victoza?
If you are looking to take Victoza, it is essential to know some of the key terms you should know. Namely, the dosage, how often to take it, and other important factors. Ordinarily, it is better to take Victoza once a day and then slowly increase the dose as needed.
What are the different types of Victoza?
There are three main types of Victoza: Bayer's Victoza, Novartis' Humira, and Roche's Humalog. Each has its specific benefits and drawbacks. Here is a brief description of each:
Bayer's Victoza is the most common type of Victoza. It is a long-acting insulin, which means you need to take it every day rather than baseline as with other types of Insulin.
Novartis' Humira is available in over 60 countries, and was developed by Novartis Pharmaceuticals and is also long-acting
Roche's Humalog is a type of insulin that can be bought online at Canadian pharmacies. It is known to be a very effective and safe insulin.
Precaution to take before Victoza?
Just like any other medication, Victoza should always be taken with caution. It is essential to be sure you are taking the correct dose and getting the maximum advantage of the medicine. If you are concerned about taking Victoza, speak with your doctor or pharmacist.
Buy Victoza online at Canadian Insulin.
Victoza pen is a medicine that is used to treat type 2 diabetes. It is also used to help control other conditions such as heart disease, arthritis, and stroke. It is essential to research the online pharmacy before purchasing because different pharmacies have different prices and shipping times for Victoza.
Canadian Insulin has a wide variety of products that are perfect for those with type 2 diabetes.
If you want a safe and effective way to manage your diabetes, buy Victoza online at Canadian Insulin may be the best option. Canadian Insulin has a long track record of being reliable and safe so you can trust its quality.
About the Creator
Sarah
With an experience of 10 years into blogging I have realised that writing is not just stitching words. It's about connecting the dots of millions & millions of unspoken words in the most creative manner possible.






Comments
There are no comments for this story
Be the first to respond and start the conversation.